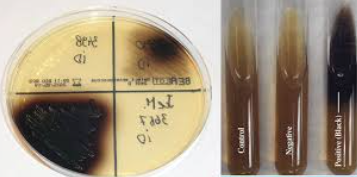
<p>Selectief en electief → vnl. voor de isolatie van Enterococcus spp. en sommige Streptococcus spp. (groep D) (uit urine) </p><p>Selectieve stoffen: galzouten en Na-azide</p><ul><li><p>Galzouten remmen de groei van de meeste grampositieve bacteriën, buiten Enterococcus spp. en groep D Streptococcus spp. </p></li><li><p>Na-azide remt de groei van gramnegatieve bacteriën </p></li></ul><p>Electieve stoffen: esculine en ijzerzouten </p><ul><li><p>Esculinenegatieve kolonies kunnen esculine niet hydrolyseren/afbreken en vertonen geen zwartverkleuring </p></li><li><p>Esculinepositieve kolonies kunnen esculine wel hydrolyseren/afbreken → afbraakproducten reageren met ijzerzouten → zwart precipitaat = zwartverkleuring → Enterococcus spp. en groep D Streptococcus spp. </p></li></ul><p></p>
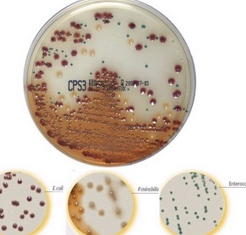
<p>Algemene bodem dat gebruikt wordt voor de isolatie van micro-organismen uit urine → semi-kwantitatieve beoordeling én directe identificatie van E. coli, Proteus en Enterococcus, en presumptieve identificatie van KESC (beter dan CLED-agar voor de isolatie van pathogenen uit urine)</p><p>Bevat tryptofaan en chromogene substraten</p><p><u>E. coli</u></p><ul><li><p>Beta-glucuronidase (of eventueel beta-galactosidase, zoals op UriSelect agar) → roze-bordeaux kolonies </p></li></ul><p><u>Proteus, Morganella, Providencia</u></p><ul><li><p>Tryptofaandeaminase → bruinverkleuring </p></li><li><p>Extra: indoltest → negatief = P. mirabilis, positief = P. vulgaris, Morganella of Providencia</p></li></ul><p><u>Enterococcus </u></p><ul><li><p>Beta-glucosidase → turquoise kolonies (grampositieve kokken) </p></li></ul><p><u>KESC </u></p><ul><li><p>Beta-glucosidase → groene tot bruingroene kolonies (gramnegatieve staven) </p></li></ul><p><u>Overige bacteriën </u></p><ul><li><p>Andere kleur/morfologie → minder typisch </p></li></ul><p></p>

1/27
Looks like no tags are added yet.
Name | Mastery | Learn | Test | Matching | Spaced | Call with Kai |
|---|
No analytics yet
Send a link to your students to track their progress
Welke micro-organismen zijn er?
Bacteriën, virussen, schimmels en gisten, algen en protozoa
Welke factoren zorgen voor een geschikte omgeving?
C-bron, N-bron, gistextract, water, voedselbestanddelen/groeifactoren (vitaminen, mineralen…)
pH, temperatuur, zuurstofgehalte, osmotische druk
Uit welke drie aspecten is de medische microbiologie opgebouwd?
Isolatie
Isoleren van pathogenen, in kweek/cultuur brengen van pathogenen → verkrijgen van losliggende kolonies dmv. zuivere cultuur of reincultuur
Identificatie (via biologische classificatie die internationaal aanvaard is)
Identificeren van de geïsoleerde pathogenen → enkel mogelijk bij reinculturen
Macroscopisch onderzoek: uiterlijke kenmerken kolonies → grootte, pigmentatie (kleurreacties), vorm, rand, hoogte, oppervlak)
Microscopisch onderzoek: RMO, gramkleuring → morfologie, onderlinge ligging of rangschikking
Biochemisch onderzoek: nagaan van de biochemische eigenschappen → elk MO heeft een eigen set aan biochemische eigenschappen = biochemische vingerafdruk
Gevoeligheidsbepaling
Bepalen van de gevoeligheid van de geïdentificeerde, geïsoleerde pathogenen
Bespreek MacConkey agar (MC, MAC). OKE
Selectief en electief
Selectieve stoffen: galzouten en kristalviolet → remmen de groei van grampositieve bacteriën
Groei van: gramnegatieve bacteriën
Electieve stoffen: lactose en neutraalrood (pH-indicator) → lactosenegatieve kolonies kleuren wit/kleurloos, lactosepositieve kolonies kleuren roze-rood (zuurproductie en lagere pH zorgen voor kleurverandering) en vertonen afname/neerslag in galzouten
Bespreek Mannitol Salt Agar (MSA). OKE
Selectief en electief
Selectieve stoffen: NaCl (hoge concentratie) → remt de groei van de meeste bacteriën, maar halotolerante bacteriën kunnen wel groeien
Groei van: Staphylococci
Electieve stoffen: mannitol en fenolrood (pH-indicator) → mannitolnegatieve kolonies kleuren wit/kleurloos (rode bodem), mannitolpositieve kolonies kleuren geel (zuurproductie en lagere pH zorgen voor kleurverandering) → S. aureus = mannitolpositief en S. epidermidis = mannitolnegatief
Bespreek cystine-lactose-elektrolyte-deficient (CLED) agar. OKE
Algemene bodem dat gebruikt wordt voor de isolatie van micro-organismen uit urine → semi-kwantitatieve beoordeling
Niet echt selectief, maar bevat cystine en is elektrolyt-deficiënt
Cystine → bevordert groei van sommige bacteriën
Lage elektrolytenconcentratie belemmert de uitzwerming van Proteus
Electieve stoffen: lactose en bromothymolblauw (pH-indicator)
Lactosenegatieve kolonies kleuren blauw/groen
Lactosepositieve kolonies kleuren geel (zuurproductie en lagere pH zorgen voor kleurverandering)
Bespreek gal-esculine agar. OKE
Selectief en electief → vnl. voor de isolatie van Enterococcus spp. en sommige Streptococcus spp. (groep D) (uit urine)
Selectieve stoffen: galzouten en Na-azide
Galzouten remmen de groei van de meeste grampositieve bacteriën, buiten Enterococcus spp. en groep D Streptococcus spp.
Na-azide remt de groei van gramnegatieve bacteriën
Electieve stoffen: esculine en ijzerzouten
Esculinenegatieve kolonies kunnen esculine niet hydrolyseren/afbreken en vertonen geen zwartverkleuring
Esculinepositieve kolonies kunnen esculine wel hydrolyseren/afbreken → afbraakproducten reageren met ijzerzouten → zwart precipitaat = zwartverkleuring → Enterococcus spp. en groep D Streptococcus spp.
Bespreek CPS-agar OKE
Algemene bodem dat gebruikt wordt voor de isolatie van micro-organismen uit urine → semi-kwantitatieve beoordeling én directe identificatie van E. coli, Proteus en Enterococcus, en presumptieve identificatie van KESC (beter dan CLED-agar voor de isolatie van pathogenen uit urine)
Bevat tryptofaan en chromogene substraten
E. coli
Beta-glucuronidase (of eventueel beta-galactosidase, zoals op UriSelect agar) → roze-bordeaux kolonies
Proteus, Morganella, Providencia
Tryptofaandeaminase → bruinverkleuring
Extra: indoltest → negatief = P. mirabilis, positief = P. vulgaris, Morganella of Providencia
Enterococcus
Beta-glucosidase → turquoise kolonies (grampositieve kokken)
KESC
Beta-glucosidase → groene tot bruingroene kolonies (gramnegatieve staven)
Overige bacteriën
Andere kleur/morfologie → minder typisch
Chocolade agar + polyvitex + VCAT OKE
Chocolade agar + polyvitex + VCAT → 37°C/CO2 → kweken van veeleisende bacteriën zoals N. meningitidis
Rijke gelyseerde bloedagar (voedingstoffen)
Aangerijkt met factor X (hemin) en V (NAD) = essentiële groeifactoren voor bepaalde bacteriën
Polyvitex = extra vitamines en groeifactoren → betere groei van fastidieuze kiemen
Selectiviteit door antibioticamengsel VCAT = vancomycine (tegen grampositieven), colistine (tegen gramnegatieven), amfotericine (tegen schimmels), trimethoprim (tegen contaminanten)
Bespreek de haemophilus chocolade-agar. OKE
Selectieve voedingsbodem voor de isolatie van Haemophilus spp. uit een mengflora
Rijke gelyseerde bloedagar (voedingstoffen)
Aangerijkt met factor X (hemin) en V (NAD) = essentiële groeifactoren voor bepaalde bacteriën
Selectiviteit: antibiotica-mengsel: bacitracine – cloxacilline
Bespreek MRSA Select. OKE
Selectief chromogeen medium voor de isolatie en directe identificatie van methicilline-resistente Staphylococcus aureus (MRSA)
Selectiviteit: antibiotica-mengsel en hoge zoutconcentratie → remt groei van andere bacteriën, bevatten vaak meticilline (of een verwant antibioticum zoals oxacilline of cefoxitine) in het medium
Bevat een chromogeen substraat voor de detectie van Staphylococcus aureus (β- glucosidase of β-galactosidase)
Bespreek Buffered Charcoal Yeast Extract (BCYE) agar. OKE
Rijk medium voor het kweken van fastidieuze bacteriën, vnl. Legionella pneumophila
Buffer → pH stabiel houden voor optimale groei
Charcoal/actieve kool → neutralisatie van toxische stoffen zoals zuurstofradicalen en vetzuren, bescherming van gevoelige bacteriën
Yeast extract/gistextract → vitamines, aminozuren en groeifactoren
L-cysteïne → essentieel aminozuur voor Legionella, groeit niet zonder cysteïne
IJzerzouten → nodig voor bacterieel metabolisme
Bespreek Salmonella-Shigella-agar (SS-agar). OKE
Selectief en electief → isolatie van Salmonella enterica en Shigella uit bijvoorbeeld stoelgang
Selectieve stoffen: galzouten en kleurstoffen, waaronder briliantgroen en natriumcitraat
Remmen de groei van grampositieve bacteriën en vele andere Enterobacteriaceae
Electieve stoffen: lactose, neutraalrood, natriumthiosulfaat en ijzerzouten
Lactose en neutraalrood: lactosenegatieve kolonies kleuren wit/kleurloos, lactosepositieve kolonies kleuren roze-rood (zuurproductie en lagere pH zorgen voor kleurverandering)
Natriumthiosulfaat en ijzerzouten: natriumthiosulfaat fungeert als S-bron, H2S-negatieve kolonies kunnen deze niet reduceren en produceren geen H2S, H2S-positieve kolonies wel → H2S reageert met ijzerionen (ijzerzouten) tot ijzersulfide = onoplosbaar en zwart van kleur → zwart precipitaat
Bespreek Xylose Lysine Deoxycholate agar (XLD-agar). OKE
Selectief en electief → isolatie van Salmonella enterica en Shigella uit bijvoorbeeld stoelgang
Selectieve stoffen: deoxycholate = galzout
Remt de groei van grampositieve bacteriën
Electieve stoffen: suikers (xylose, lactose, sucrose), fenolrood, lysine, natriumthiosulfaat en ijzerzouten
Suikers (xylose, lactose, sucrose) en fenolrood: niet-suikerfermenterende kolonies kleuren rood, suikerfermenterende kolonies kleuren geel (zuurproductie en lagere pH zorgen voor kleurverandering)
Lysine: kolonies die lysinedecarboxylatie kunnen uitvoeren kleuren rood (basenproductie en hogere pH zorgen voor kleurverandering) → Salmonella enterica!
Natriumthiosulfaat en ijzerzouten: natriumthiosulfaat fungeert als S-bron, H2S-negatieve kolonies kunnen deze niet reduceren en produceren geen H2S, H2S-positieve kolonies wel → H2S reageert met ijzerionen (ijzerzouten) tot ijzersulfide = onoplosbaar en zwart van kleur → zwart precipitaat
Bespreek Cefsulodin-Irgasan-Novobiocin (CIN) agar.
Selectief en electief → isolatie van Yersinia enterocolitica uit klinische en voedselmonsters
Selectieve stoffen: mix van antibiotica
Remt de groei van de meeste Enterobacteriaceae en Pseudomonas spp.
Cefsulodin → antibioticum dat specifiek de groei van gramnegatieve bacteriën remt, irgasan (triclosan) → breedspectrum antimicrobieel middel dat de groei van begeleidende flora remt, novobiocin → antibioticum dat grampositieve en sommige gramnegatieve bacteriën remt
Selectieve stoffen: deoxycholate = galzout
Remt de groei van grampositieve bacteriën
Electieve stoffen: mannitol en neutraalrood
Mannitol en neutraalrood: mannitolnegatieve kolonies (die kunnen groeien) kleuren wit/kleurloos, mannitolpositieve kolonies kleuren dieprood (zuurproductie en lagere pH zorgen voor kleurverandering) → Y. enterocolitica vormt kolonies met een dieprood centrum en een transparante rand = bull’s eye

Bespreek Schaedler agar OKE
Bespreek Thiosulfaat Citraat Bile Sucrose (TCBS) agar. OKE
xxx
Bespreek de oxidasetest. OKE
Biochemische test die de aanwezigheid van cytochroom c oxidase in het MO nagaat.
Cytochroom c oxidase speelt een belangrijke rol in de ademhalingsketen (brengt zuurstof in de cel via oxidatie van cytochroom c)
Essentieel voor aerobe bacteriën
Wanneer het reagens (tetramethyl-p-fenyleendiamine, kleurloos) wordt toegevoegd, zal deze binnen 10-20 seconden geoxideerd worden door oxidasepositieve bacteriën naar indofenolblauw, dat gekenmerkt wordt door een donkerpaarse, bijna zwarte kleur.

Bespreek de Kligler test. OKE
De Kligler Iron Agar test (KIA-test) of de Triple Sugar Iron test (TSI-test) is een biochemisch gecombineerd testmedium, waarmee gramnegatieve darmbacteriën (Enterobacteriaceae) geïdentificeerd kunnen worden op basis van suikerfermentatie, gasproductie en H2S-productie.
De ingrediënten van het medium van de buis bestaan uit:
Peptonen (N-bron en voedingstoffen)
Kleine hoeveelheid glucose (0,1%), lactose (1%), en bij TSI ook sucrose
Fenolrood (pH-indicator)
Thiosulfaat (S-bron) en ijzerzouten
De buis heeft een stomp of butt aan de bodem, en een schuine kant aan de oppervlakte, oftewel een helling of slant.
De helling/slant is zuurstofrijk → zuurstofrijke afbraak van suikers.
De stomp/butt is zuurstofarm → fermentatie of zuurstofarme afbraak van suikers.
Principe: glucose - gas - lactose - H2S
Glucose: Eerst zal glucose gefermenteerd worden en zal dit het hele medium aanzuren (geel). Er is echter weinig glucose en hierdoor zullen bacteriën na een tijd overschakelen op de afbraak van de peptonen (proteolyse) en hierbij basen produceren (rood). Voornamelijk ter hoogte van de helling zal dit zichtbaar worden omdat de zuurstofrijke omgeving de proteolyse aanzienlijk bevordert.
Gas: Bij fermentatie komt gas vrij, dat zich uit in scheuren of bellen in de agar.
Lactose: Lactosepositieve bacterïen zullen lactose kunnen fermenteren en dit zal opnieuw het hele medium aanzuren (geel).
H2S: H2S-positieve bacteriën kunnen thiolsulfaat reduceren en H2S produceren → H2S reageert met ijzerionen (ijzerzouten) tot ijzersulfide = onoplosbaar en zwart van kleur → zwart precipitaat
5 verschillende types kunnen bekomen worden:
Coli-type: + + + -
Paracoli-type: + + - -
Shigella-type: + - - -
Salmonella-type: + (+) - +
Citrobacter freundii type: + + + +

Bespreek de MIU-test OKE
De MIU-test is een biochemisch gecombineerd testmedium, waarmee gramnegatieve darmbacteriën (Enterobacteriaceae) geïdentificeerd kunnen worden op basis van motiliteit, indolevorming en urease-activiteit.
Principe:
Motiliteit: Troebele verspreiding van de bacterie vanuit de entlijn
xxx
Bespreek de gelatinasetest. OKE
De gelatinasetest of de gelatinehydrolysetest bepaalt of bacteriën het enzym gelatinase produceren.
Gelatinase = extracellulair enzym dat gelatine afbreekt (hydrolyseert) tot aminozuren
Medium bevat voedingsgelatine en stolt bij lage temperaturen
Na enting en incubatie wordt de buis in een ijsbad of koelkast gepplaatst
Gelatinasepositief → medium blijft vloeibaar na koeling (vloeibaarwording of liquefactie) = gelatine is afgebroken
Gelatinasenegatief → medium stolt na koeling = gelatine is nog steeds intact
Wordt gebruikt voor de identificatie van oa. Serratia
Wordt gebruikt voor de differentiatie van S. aureus (positief) van S. epidermidis (negatief)
Bespreek de ureasetest. OKE
Bepaalt of bacteriën het enzym urease produceert.
Urease splitst ureum in ammoniak en koolstofdioxide en de toename in ammoniak zorgt voor een verhoging van de pH.
Fenolrood wordt meestal als pH-indicator gebruikt.
Ureasepositief → vorming ammoniak en verhoging van de pH → dieproze, rode kleur
Ureasenegatief → geen vorming van ammoniak en geen verhoging van de pH → geel, oranje kleur blijft behouden
Oorspronkelijke pH was neutraal, eerder zuur → vandaar reeds in het begin geel, oranje

Bespreek de indooltest. OKE
Bepaalt of de bacterie het enzym tryptofaanase bezit.
Tryptofaanase zet het aminozuur tryptofaan om in indool, pyruvaat en ammoniak → desaminatie en verdere afsplitsing van zijketens totdat indool overblijft
Medium bevat tryptofaan (bvb. SIM, MIU)
Na incubatie wordt het Kovacs-reagens toegevoegd → reageert met indool
Indoolpostief → rode ring aan de oppervlakte
Indoolnegatief → de laag blijft geel/bruin

Bespreek de mannitoltest OKE
Bepaalt of de bacterie mannitol kan fermenteren
Medium bevat mannitol en fenolrood
Mannitolpositef → mannitolfermentatie en zuurproductie → pH daalt → medium kleurt geel
Mannitolnegatief → geen mannitolfermentatie en zuurproductie → pH blijft onveranderd → medium blijft rood/roos
Hoe wordt het halofiel karakter nagegaan van een bacterie nagegaan worden? OKE
Nagaan of een bacterie zout (NaCl) nodig heeft om te groeien
Kiem wordt uitgeënt op kweekmedia met verschillende NaCl-concentraties: van 0% naar 12%
Wanneer de bacterie enkel kan groeien met NaCl, is deze strikt halofiel → andere Vibrio’s
Wanneer de bacterie kan groeien zonder NaCl, is deze niet (of minder) strikt halofiel → Vibrio cholerae
Wanneer de bacterie kan groeien in een hoge NaCl-concentratie, is deze halotolerant
Bespreek de bèta-lactamasetest voor Haemophilus influenzae.
Nagaan of H. influenzae bèta-lactamase produceert → breekt bèta-lactam-antibiotica af door de bèta-lactamring door te knippen
Chromogeen substraat (meestal nitrocefine) → lijkt op een bèta-lactam-antibioticum
Afbraak van substraat → kleurverandering (rood) → bèta-lactamase aanwezig
Geen afbraak van substraat → geen kleurverandering (geel) → bèta-lactamase niet aanwezig
Bespreek de hippuraathydrolysetest (Campylobacter). OKE
De test gaat na of een bacterie hippuraat kan afbreken.
Hippuraat wordt door het enzym hippuricase gehydrolyseerd tot glycine en benzoëzuur
Wanneer glycine reageert met het reagens ninhydrine, zal er een paarse kleur gevormd worden
Campylobacter jejuni is positief → paarse kleur
Campylobacter coli en alle anderen zijn negatief → geen kleurverandering
Bespreek de indoxyl-acetaat hydrolysetest. OKE
De test gaat na of een bacterie indoxyl-acetaat kan hydrolyseren met esterasen.
Het substraat indoxyl-acetaat wordt gehydrolyseerd door esterase → indoxyl → oxideert spontaat → blauwgroen eindproduct
Campylobacter jejuni, coli en upsaliensis = positief → bevatten esterase → vorming blauwgroene kleur
De rest = negatief → bevatten geen esterase = negatief → geen kleurverandering